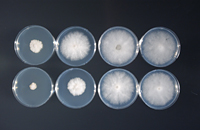

Reviewed 2012.
Phytophthora root and stem rot of soybean
Phytophthora sojae
Soybean: Glycine max, the cultivated soybean, is the primary economic host. Glycine soja, the wild progenitor of soybean, is also susceptible

Figure 1a |

Figure 1b |
Symptoms and Signs
Phytophthora root and stem rot is caused by the oomycete plant pathogen Phytophthora sojae. This water mold can infect seeds, seedlings, and plants in all reproductive stages of growth when soil conditions favor pathogen development. Symptoms usually become apparent one to two weeks after heavy rains and are most common on soils that are poorly drained.
Seed rot and damping-off. Phytophthora sojae causes seed decay, and pre- and post-emergence damping-off (Figure 2) of soybeans under wet and warm soil conditions. The optimum temperature for disease development is 25 to 30°C (77 to 86°F). Fields with extensive seed rot and pre-emergence damping-off often require replanting. A light brown soft rot may develop on roots or the hypocotyl as seedlings emerge from the soil. As the roots and or hypocotyls become colonized, the seedlings may die.

Figure 2 |
Root and stem rot. The severity of the infection on soybean plants in the vegetative and reproductive stages of growth is directly related to the level of resistance in the plant. In highly susceptible cultivars, P. sojae colonization begins in the roots, then spreads several nodes up the stem. The roots and stem turn a chocolate brown color, the leaves of the plant turn yellow, and the whole plant turns a reddish-orange to orange-brown color. Occasionally a lesion will only occur on one side of the plant, but it is continuous from below the soil line up the plant. The yellowed, wilted leaves cling to the plant as it dies (Figure 3). In highly susceptible cultivars, virtually every plant in the field may be killed during the course of the production season; cultivars with moderate to low levels of partial resistance may suffer between 20 and 50% stand loss. For cultivars with higher levels of partial resistance, the stem rot phase does not develop. Roots are still colonized and are light brown in color, and in some cases the plants may be stunted. There are usually no visible symptoms, other than reduced yields, under field conditions for cultivars with high levels of partial resistance.

Figure 3 |
Pathogen Biology
Phytophthora sojae is an oomycete, a close relative of the golden brown algae, in the Kingdom Stramenopila (or Straminipila). This group of organisms produces swimming spores (zoospores) which have tubular flagella. While oomycetes have little taxonomic affinity to fungi, they are “fungus-like” in their growth since they also produce mycelium. The mycelium is coenocytic (aseptate – lacking cross walls) but as a laboratory culture ages, false septae will form. Lima bean agar (Figure 4) is one of the most common media used to culture P. sojae; on it, the mycelium grows close to the agar surface and has no color. Interestingly, P. sojae does not grow on full strength potato dextrose agar, a commonly used medium for many fungi and oomycetes. Reducing the concentration of potato dextrose agar and supplementing with water agar improves the growth (Figure 5). On V8 juice agar medium, the hyphae are white and branch mostly at right angles. The optimum temperature for growth of most isolates on any medium is 25 to 28°C (77 to 82°F).

Figure 4 |
Figure 5 |
On lima bean agar, oospores (thick-walled, sexual spores) form readily, often within 3 to 4 days. Phytophthora sojae is homothallic (self-fertile). Antheridia (male structures) are predominantly paragynous (attach to the side of the oogonial stalk), but some will be amphigynous (encircle the oogonial stalk). Oospore walls are smooth and the oogonia are 40µm in diameter, sometimes as large as 45µm (Figure 6a, Figure 6b)

Figure 6a |

Figure 6b |
Sporangia (thin-walled lemon-shaped spores) do not form in agar culture but can be induced with repeated flooding and washing of cultures (Qutob et al., 2000; Schmitthenner and Bhat, 1994). Once formed, a sporangium has an inconspicuous papilla (a small rounded process on the tip) so it appears nonpapillate. Sporangia have long pedicels and are non-caducous (do not shed or break off from main mycelium) (Figure 7). Sporangia are approximately 40 µm long by 28 µm wide. Germination is either direct by production of hyphae or indirect by the production of large numbers of zoospores (>20). From the empty sporangium, another sporangium will develop in an extended and nested pattern.

Figure 7 |
Zoospores swim toward the root and encyst on the root surface. A single germ tube emerges and penetrates the root cell wall.
Nomenclature
Phytophthora sojae can readily be mistaken for Phytophthora megasperma. In fact, at one time, P. sojae and P. medicaginis were known as Phytophthora megasperma f. sp. glycines and P. megasperma f. sp. medicaginis, respectively. Molecular analysis of the mitochondrial region (Forster et al., 1989) and isozyme analysis (Nygaard et al., 1989) provided evidence that these were in fact distinct species.
P. sojae has a gene-for-gene relationship with its host, soybean. Fourteen different single resistance genes, designated Rps genes, have been described (Grau et al., 2004). A number of sets of differential cultivars are available to characterize pathotypes (races) of P. sojae. These sets were developed by backcrossing different sources of resistance into common genetic backgrounds (Williams, Bedford, Harosoy and Corsoy) to develop isolines, i.e., varieties that are almost identical to each other, except that they differ in one resistance gene. There are 55 coded races, but many more virulence combinations have been described in the US. Many publications today refer to the pathotype, the exact listing of virulence reactions that each isolate has on the isolines of the differential set rather than a race code number, as the number of races and diversity has become too great. A pathotype is determined by inoculating an isolate on the series of differentials. If a spreading brown lesion forms following an inoculation (compatible or susceptible interaction) on a differential carrying a specific R-gene, then that response becomes part of the pathotype. For example, isolates that are designated Race 30 cause susceptible responses on differentials with Rps1a, Rps1b, Rps1k, Rps3a, Rps6 and Rps7. A brief listing of races and their corresponding pathotype is shown in Table 1.
Table 1. Race designationsa, corresponding pathotypes, and reactions following inoculation of R-gene specific differentials used to characterize Phytophthora sojae.
| Race |
Pathotype |
rps |
Rps1a |
Rps1b |
Rps1c |
Rps1d |
Rps1k |
Rps3a |
Rps6 |
Rps7 |
| 1 |
7 |
S |
R |
R |
R |
R |
R |
R |
R |
S |
| 2 |
1b, 7 |
S |
R |
S |
R |
R |
R |
R |
R |
S |
| 3 |
1a, 7 |
S |
S |
R |
R |
R |
R |
R |
R |
S |
| 4 |
1a, 1c, 7 |
S |
S |
R |
S |
R |
R |
R |
R |
S |
| 10 |
1b, 3a, 7 |
S |
R |
S |
R |
R |
R |
R |
R |
S |
| 17 |
1b, 1d, 3a, 6, 7 |
S |
R |
S |
R |
S |
R |
S |
S |
S |
| 25 |
1a, 1b, 1c, 1k, 7 |
S |
S |
S |
S |
R |
S |
R |
R |
S |
| 30 |
1a, 1b, 1k, 3a, 6, 7 |
S |
S |
S |
R |
R |
S |
S |
S |
S |
| 31 |
1b, 1c, 1d, 1k, 6, 7 |
S |
R |
S |
S |
S |
S |
R |
S |
S |
| 35 |
1a, 1b, 1c, 1d, 1k |
S |
S |
S |
S |
S |
S |
R |
R |
R |
| 36 |
3a, 6 |
S |
R |
R |
R |
R |
R |
S |
S |
R |
| 45 |
1a, 1b, 1c, 1k, 6, 7 |
S |
S |
S |
S |
R |
S |
R |
S |
S |
| 51 |
1c, 6, 7 |
S |
R |
R |
S |
R |
R |
R |
S |
S |
| 55 |
1d, 3a, 6, 7 |
S |
R |
R |
R |
S |
R |
S |
S |
S |
aDesignations for race were based on the response of differentials, in which R indicates a resistant response (no lesion develops) and S indicates a susceptible response (spreading brown lesion).
Disease Cycle and Epidemiology
 Disease Cycle
Disease Cycle
Phytophthora sojae is a soilborne plant pathogen that survives as oospores in soil and plant debris. Oospores can survive for a number of years in a dormant state, and can withstand freezing and long periods of cold temperatures. Oospores of P. sojae have endogenous dormancy and not all will germinate at the same time even when conditions are highly favorable. Oospores germinate to form mycelia under high soil moisture conditions, and this mycelium then produces sporangia and zoospores under continued or subsequent saturated soil conditions. Zoospores are attracted to soybean roots, specifically to the soybean specific root exudates daedzein and genestein (Morris and Ward, 1992). Once they reach a root, the zoospores lose their flagella, produce a cell wall (encyst), germinate, and subsequently infect root tissues. P sojae colonizes the root and stem tissues where it produces oospores.
Phytophthora sojae is readily baited from soils collected at any time of year. To bait, soils are planted with susceptible soybean lines and flooded for 24 hours (Figure 8). Seedlings with characteristic symptoms can be collected and the pathogen isolated from infected tissues. Alternatively, soils can be submerged and leaf discs floated on the surface to capture zoospores, then leaf discs can be plated on selective medium. However, soils which are dry or have been frozen require saturation followed by an incubation period of 1 to 2 weeks of continuous moist conditions and temperatures of 60-65°F. This incubation period helps “break” dormancy of the oospores.

Figure 8 |
Soybean root and stem infections can occur throughout the season and are thought to arise directly from oospores. In most fields, inoculum of the pathogen survives as oospores, often in high numbers. The diseases caused by P. sojae are considered monocyclic, i.e., having only one effective infection cycle per growing season, primarily due to the nature of oospores which do not all germinate at one time. The role of secondary (root-to-root) inoculum in enhancing disease severity is largely unknown. Infection often appears random; in the field it is common to see one symptomatic plant, then 10 healthy plants followed by another symptomatic plant. Conversely, large areas of damping-off can occur in low areas of a field or areas with reduced drainage (Figure 9).

Figure 9 |
Disease Management
Phytophthora sojae is prevalent in many soybean production regions of the world and is managed primarily with host resistance. P. sojae consists of many races but the occurrence of these races or virulence pathotypes is quite variable across the north central region of the United States both within fields and between fields. This diversity of pathotypes can make soybean cultivar selection challenging for producers.
Host resistance
Several types of resistance have been described in the P. sojae-soybean pathosystem: R-gene mediated resistance, root resistance, and partial resistance. R-gene mediated resistance has been described for 14 Rps genes and most have been mapped on the soybean genome. Commercially, only six genes, Rps1a, Rps1b, Rps1c, Rps1k, Rps3a and Rps6, have been deployed and one more, Rps8, is in commercial development. This type of resistance is expressed as a hypersensitive response and is most often measured in laboratory and greenhouse assays through inoculation of the hypocotyl region on young seedlings. However, it is only effective against some races (see Pathogen Biology page).

Figure 10 |
Root resistance and partial resistance are both expressed in the roots. Root resistance is almost a complete resistance that is expressed in the roots but is quantitatively (several genes that each contribute to the level of resistance) inherited. Partial resistance is also quantitatively inherited and is primarily expressed as reduced colonization of the roots.

Figure 11 |
Partial resistance is expressed in plants after the cotyledons and first true leaves are visible, but Rps gene resistance is expressed in the seed and therefore is effective from germination onwards. Partial resistance is expressed as reduced colonization and slower lesion expansion, and is inherited as a multi-genic trait. Since more genes are involved in the expression of this resistance and the assays take longer, partially resistant cultivars are more difficult to breed. A combination of Rps gene and partial resistance has provided the best protection, especially in regions where individual fields may harbor a large number of races.
Chemical control
Fungicide seed treatments are the only chemical control practiced to manage P. sojae and they are used for managing early season seed decay and damping-off. Mefenoxam and metalaxyl, two very similar compounds, can both be used as seed treatments. For adequate management of P. sojae, higher rates of seed treatment product have higher efficacy than low rates. Many oomycete species have been identified that have adapted to these fungicides and are no longer sensitive. However, the north central region of the United States was surveyed from 2001 to 2005 for the presence of metalaxyl/mefenoxam-insensitive isolates of P. sojae, but none were found.

Figure 12 |
Cultural practices
Phytophthora root rot is more severe in poorly drained or flooded areas of the field. Any cultural practice that improves soil drainage ultimately reduces the time that soils are saturated, and thus reduces the infection period. Soil tillage and placing drain tiles in fields either in combination or alone may reduce the incidence and severity of Phytophthora root and stem rot (Figure 13). Rotation and tillage are not effective management options since the oospores of P. sojae are capable of surviving for long periods of time in soil.

Figure 13 |
Significance
Phytophthora root rot is a problem worldwide on poorly drained soils (Costamilan et al., 1996; Jee et al., 1998; Wrather et al., 2001; Yanchun and Chongyao, 1993). The disease was identified in the US in Indiana in 1948 and again in Ohio in 1951 as soybean production was beginning to take off; however the causal agent was not described until 1958 (Kaufmann and Gerdemann, 1958).
In the US, this is probably the best managed soybean disease, as most cultivars have some level of resistance to P. sojae, either as an Rps gene alone or combined with partial resistance (Figure 14, Figure 15). Historically this was not always the case. Cultivars that were planted during the late 1970s had a single resistance gene, Rps1a. New races developed that killed plants with this gene. Ohio lost 300,000 acres in one year alone. As a result, single genes and partial resistance were widely deployed starting in the 1980s and still are relied upon today (Schmitthenner, 1985).
There has been much speculation about where P. sojae originated (Schmitthenner, 1988). It was only recently described from the Republic of South Korea or the People’s Republic of China, in1998 and 1993, respectively. However, the diversity of resistance, both in numbers of Rps genes and levels of partial resistance in soybeans, is much higher in soybean lines from the Republic of South Korea and some provinces in China than in plant material originating elsewhere.

Figure 14 |

Figure 15 |
Selected References
Costamilan, L.M, E.R. Bonato, A.F. Urben, K. Matsuoka, and C.A. Vanetti. 1996. Ocorrência de Phytophthora sojae no Brasil. Fitopatologia Brasileira, v.21:395.
Dorrance, A.E., H. Jia, and T.S. Abney. 2004. Evaluation of soybean differentials for their interaction with Phytophthora sojae. Plant Health Progress. doi:10.1094/PHP-2004-0309-01-RS.
Erwin, D.C. and O.K. Ribeiro. 1996. Phytophthora Diseases Worldwide. APS Press, St. Paul MN.
Förster H., T.G. Kinscherf, S.A. Leong, and D.P. Maxwell. 1989. Restriction fragment length polymorphisms of the mitochondrial-DNA of Phytophthora megasperma isolated from soybean, alfalfa, and fruit trees. Canadian Journal of Botany 67:529-537.
Grau, C.R., A.E. Dorrance, J. Bond, and J.S. Russin. 2004. Fungal Diseases. Pages 679-763 in: Soybeans: Improvement, Production, and Uses, 3rd ed. Agronomy Monograph no. 16. H.R. Boerma and J.E. Specht, eds.
Jee, H., W. Kim, and W. Cho. 1998. Occurrence of Phytophthora root rot on soybean (Glycine max) and identification of the causal fungus. Crop Protection 40:16-22.
Kaufmann, M.J., and J.W. Gerdemann 1958. Root and stem rot soybean caused by Phytophthora sojae n. sp. Phytopathology 48:201-208.
Morris, P.F., and E.W.B. Ward. 1992. Chemoattraction of zoospores of the soybean pathogen, Phytophthora sojae, by isoflavones. Physiological and Molecular Plant Pathology 40:17-22.
Nygaard, S.L., C.K. Elliott, S.J. Cannon, and D.P. Maxwell. 1989. Isozyme variability among isolates of Phytophthora megasperma. Phytopathology 79:773-780.
Qutob, D., P.T. Hraber, B.W. Sobral, and M. Gijzen. 2000. Comparative analysis of expressed sequences in Phytophthora sojae. Plant Physiology 123: 243-254.
Schmitthenner, A.F. 1988. Phytophthora rot of soybean. Pages 71-80 in: Soybean Diseases of the North Central Region, T.D. Wyllie and D.H. Scott, eds. APS Press, St. Paul, MN.
Schmitthenner, A.F. 1985. Problems and progress in control of Phytophthora root rot of soybean. Plant Disease 69:362-368.
Schmitthenner, A.F. and R.G. Bhat. 1994. Useful Methods for Studying Phytophthora in the Laboratory. The Ohio State University, OARDC, Wooster, OH. 10pp.
Wrather, J.A., T.R. Anderson, D.M. Arsyad, Y. Tan, L.D. Ploper, A. Porta-puglia, H.H. Ram, and J.T. Yorinori. 2001. Soybean disease loss estimates for the top ten soybean producing countries in 1998. Canadian Journal of Plant Pathology 23:115-121.
